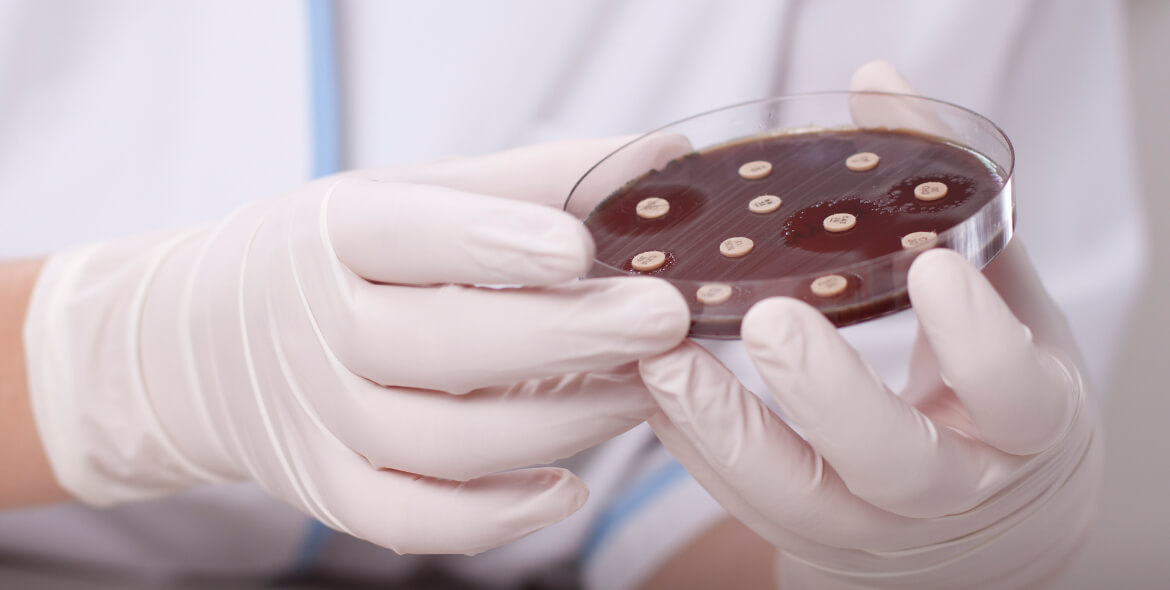

抗菌产品的趋势
环境中微生物与每个人的生活息息相关,小至影响着个人的体味表现,大至身体健康状态与否,举例来说,于 1995 年世界卫生组织统计,全球因细菌感染而死亡的人数为 1,700 万人,约占全球死亡人数的三分之一,1996 年日本曾发生全球最大规模食物中毒事件,感染源为大肠杆菌 O157:H7 型 (Escherichia coli O157:H7),造成 17,000 人感染、13 人死亡,或是妇女常常反复感染白色念珠菌与现今所面临的超级细菌及空调病等问题,都和微生物有相当密切的关系。
因应民众越来越重视健康,各式抗菌产品油然而生,如:抗菌砧版、抗菌液、抗菌纤维、抗菌口罩、抗菌磁砖、抗菌卫生棉、抗菌干洗手、紫外线灯、光触媒灯等产品受到更多重视,相关产品亦多元化发展。
宣称抗菌防霉的注意事项
产品之抗菌防霉功效并非随意可宣称及标注使用的,必需经由公正单位制订方法,并由专业可信赖的实验室进行抗菌试验评估而得之。
抗菌的定义:能在一定时间内,使某些微生物 (包含细菌) 的生长或繁殖保持在必要水平以下之化学作用。
常见抗菌等相关名词定义
灭菌:杀灭或除去所有微生物
杀菌:杀死微生物
消毒:消灭具特定病原性之微生物,并未杀死所有微生物
除菌:去除微生物
制菌:阻碍或抑制特定微生物的繁殖
静菌:阻碍或阻止微生物的增殖
防霉:抑制霉菌的发生成长或繁殖
抗菌:抑制微生物之发生成长或繁殖
抗菌产品的生产
抗菌产品之研发,多采添加抗菌剂于产品中,或是于表面加工,常使用之抗菌剂,如:有机抗菌剂、无机抗菌剂、天然抗菌剂及高分子抗菌剂;而所适用的材料,如:抗菌塑料、玻璃、陶瓷、纸张、纺织品或是金属材料等。
如何评估有无抗菌防霉的效果?
抗菌防霉可经由微生物试验得知其效果,试验可分为定性及定量试验,测试菌种一般常使用金黄色葡萄球菌、大肠杆菌、绿脓杆菌、巴西曲菌(黑曲菌)以及白色念珠菌等。
常见检验方法有 JIS、AATCC、ASTM、ISO 与 CNS,不同的检体型态各有其适用之检验方法,另外,于市面上偶而可见之抗菌报告以参考美国药典 USP 51 方法来进行抗菌评估,其完整名称为「Preservative Challenge Test for Personal Care Products」,目的是为了评估「化妆品或个人用品中防腐剂的添加是否可以在试验期间能有效抑制细菌的滋长」,该方法并不适用于抗菌试验的评估。
抗菌试验流程
抗菌试验系指检测试验物质本身抑制或杀死微生物之能力,试验之材料会依据不同适用之方法而有所调整,抗菌试验流程主要包含了五个部分:
1、检体前处理:检体清洁及消毒。
2、试验菌液制备:菌株活化及试验菌株悬浮液调制。
3、试验菌液接种:依试验文献接种菌液体积及符合培养条件。
4、检测步骤:检测试验组及对照组所残留之菌量。
5、抗菌效能评估:经由残留菌量推演出抗菌效能及是否符合文献之标准。
台美检验抗菌试验特点
为了带给您更完善的抗菌测试服务,台美检验 (SuperLab) 建立了高达 40 种以上的测试菌株供您选择,让您的菌株选择更能多元化,而不在局限于少数某些菌株选择。